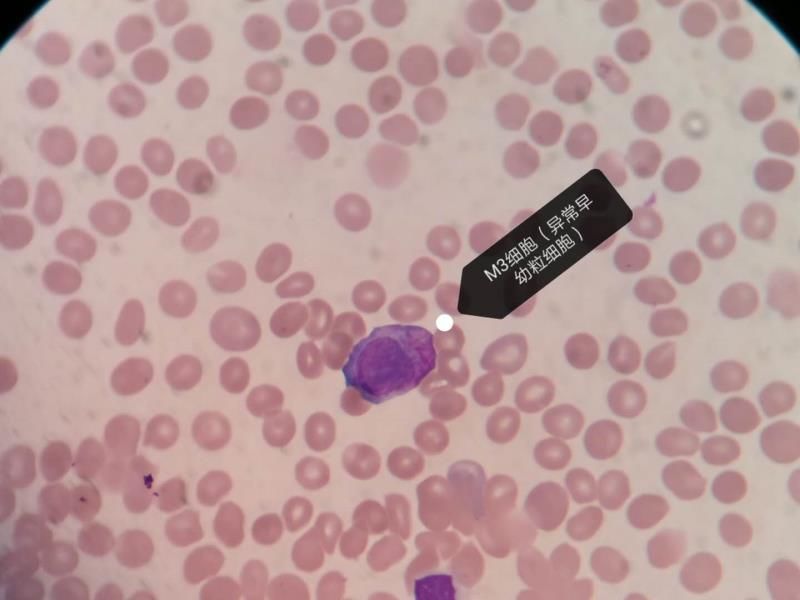

血常规涂片规则——初筛血癌的第一道防线
张金彪
河北省沧州中西医结合医院实验诊断科
1前 言
血常规检测是白血病的窗口,能够在早期发现白血病细胞。
目前,五分类血细胞分析仪已经普及各家基层医院,仪器精密分析和报警提示,再加上我们设置的复检规则,为初筛白血病细胞提供了保障。
但现在普遍存在的问题就是人员素质参差不齐。仪器设备的快速发展、检验技术的不断更新,人员素质相对落后。究其原因有几何?是检验人员的进步跟不上科技发展?还是检验人员逐步在忽视人工镜检?
下面是一例通过血常规初筛到白血病细胞,通过本病例再次给检验人员发出“警告信号”:镜检不能丢。
2案例经过
患者,女,18岁,因皮肤散在出血点就诊于皮肤科,经询问,患者还有胃肠道不适,医生开具血常规、尿常规和粪便常规检查,检查结果:尿常规正常,便常规隐血阳性,血常规结果异常如下:


1、检测结果两系明显异常,单核比例相对增高。
2、白细胞散点图分界不清,提示有幼稚细胞存在。
血常规中白细胞、血小板数量减低,单核细胞比例相对增高,幼稚细胞增高,分析原因可考虑:
1. 白细胞减少症?
2. 标本凝集了?
3. EDTA依赖性血小板假性减低?
4. 单核细胞比例增高,又提示有幼稚细胞,存在幼稚的单核细胞?
5. 白细胞散点图分界不清,幼稚细胞影响?
6. 仪器报警信息:WBCCOUNT? Platelet Flags?PLT??
首先我们进行了复检规则,涂片后镜检结果如下:


我们发现血小板并未聚集,低倍镜下观察片中有核细胞数量较少,在浏览血膜周边时,发现有异常细胞可能。换油镜下发现如下图异常细胞。

最终我们通过复检,在血常规报告单复检一栏提示:片周看见幼稚细胞,高度考虑异常早幼粒细胞(M3细胞),即急性早幼粒细胞白血病,建议临床及时关注,给予处理。
3经验总结
01
血常规结果异常,首先要结合患者信息作初步分析,如年龄、性别、就诊科室等,以上信息有时会提示易发病;该病例为男性、18岁,就诊皮肤科,考虑初诊血液病方面可能较大。
02
血常规结果异常,联系临床,获得更多患者的临床特点是必要的,初诊还是复诊,患者还有哪些表现,对我们结合检测结果给出合理性建议是很关键的。该病例除了皮下出血点外,还有胃肠道不适,粪便潜血阳性,考虑肠道有出血,这也是AML-M3患者出血的另一大临床特点。
03
外周血单独一系减低和伴随多系减低,临床诊断价值有很大区别,要注意单项指标异常和多项指标异常的综合性分析。
04
血常规复检规则的建立、验证、记录、存片是四大必要元素,读片方法不能忽视,片子中间不容易发现异常细胞,片尾和片周是异常细胞尤其是大个儿细胞存在的区域,所以,严格执行复检规则可有效避免白血病或血液疾病的漏诊,减少医疗事故。
05
检验人员并非操作工,通过实验协助诊断,医学检验换位检验医学,为患者及临床提供及时准确的检验结果和指导建议。该病例最终确定为急性早幼粒细胞白血病,本病凶险之处即为出血,极易并发DIC,早期的诊断可给挽救患者生命更多机会和时间。我们报告血常规结果的同时,立即建议临床马上检测凝血功能,评估患者出血风险。
血常规作为筛查“血癌”的第一道防线其作用不言而喻,再精密的仪器也代替不了人工镜检。该患者已及时收入住院,接受相关治疗。
范洪专家点评
检验人员要注重基础操作,基础操作包括仪器设备的定标、质控、性能验证、比对、维护和维修,形态学是更是不可丢的基础,血细胞形态识别每个检验人员都应会,复检规则不能形同虚设,不然无法保证血常规检验质量。本病例是通过复检规则早期发现的一例AML-M3,并给于临床指导建议,为患者的诊治争取了时间。本文客观真实,可以供鉴。

